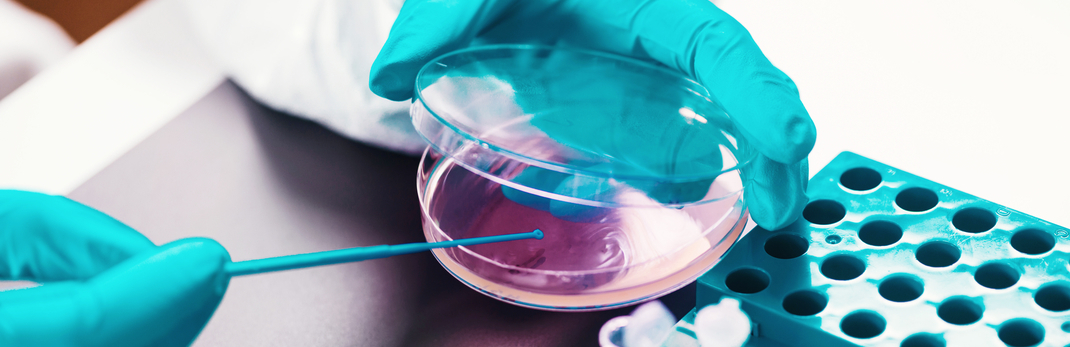
campylobacter sampling EU

From 1 January 2018, companies in the European Union member states involved in the production of poultry meat are required to comply with both the new Campylobacter limits and the standardised testing procedures or face punishment for violations.
Comply with both the new Campylobacter limits and the standardised testing procedures, or face punishment for violations
The amendment to Regulation (EC) No 2073/2005 brings Campylobacter sampling processes, limits and corrective actions, in line with similar microorganisms, such as Salmonella and Listeria, which have been regulated since 2005.
It is important to note that “these criteria are not applicable to the products placed on the market; they set an indicative contamination value above which corrective actions are required in order to maintain the hygiene of the process in compliance with the legislation”1 .
The main change for poultry producers is a requirement to comply with a limit of 1000 cfu/g.
| Food category | Micro-organisms | Sampling plan | Limits | Analytical reference method | Stage where the criterion applies | Action in case of unsatisfactory results | ||
|---|---|---|---|---|---|---|---|---|
| n | c | m | M | |||||
| 2.1.9 Carcases of broilers | Campylobacter spp. | 50 (5) | From 1.1.2018 c = 20; From 1.1.2020 c = 15; From 1.1.2025 c = 10 | 1 000 cfu/g | EN ISO 10272-2 | Carcases after chilling | Improvements in slaughter hygiene, review of process controls, of animals' origin and of the biosecurity measures in the farms of origin | |
Figure: Table represents Chapter 2, Section 2.1, row 2.1.9: Annex I to Regulation (EC) No 2073/20051 . © European Union.
n = number of units comprising the sample;
c = number of sample units giving values over m or between m and M.
- From 1 January 2018 to 31 December 2019: c =20
- After 1 January 2020: c =15
- After 1 January 2025: c = 10
Campylobacter Sampling Requirements
The sampling plan for Campylobacter should follow the established approach for Salmonella in poultry carcases.
Poultry plants should perform a microbiological analysis at a minimum frequency of once per week, changing the day of sample selection each week to ensure all days are covered. The same neck skin samples used for testing for Salmonella can also be used for Campylobacter analyses.
When the tests for Salmonella and Campylobacter are carried out in the same laboratory, neck skins from a minimum of 15 poultry carcases are to be sampled at random after chilling during each sampling session. Before examination, the neck skin samples from at least three poultry carcases from the same flock of origin are to be pooled into one sample of 26 g.
When the tests for Salmonella and Campylobacter are carried out in two different laboratories, neck skins from a minimum of 20 poultry carcases are to be sampled at random after chilling during each sampling session. Before examination, the neck skin samples from at least four poultry carcases from the same flock of origin are to be pooled into one sample of 35 g.
If satisfactory results for Campylobacter have been obtained for 52 consecutive weeks, the sampling frequency may be reduced to fortnightly after authorisation by the relevant local authority and seasonal variation adjustments may also be possible.
Detailed sampling procedures can be found here, here, and are reflected in ISO 10272-2:2017 Microbiology of the food chain -- Horizontal method for detection and enumeration of Campylobacter spp. -- Part 2: Colony-count technique.
What are the implications for failing to comply?
As stated in the regulation, in the instance of a failed sample, corrective actions include “improvements in slaughter hygiene, review of process controls, of animals' origin and of the biosecurity measures in the farms of origin”. An example of corrective actions is described in “The European Union summary report on trends and sources of zoonoses, zoonotic agents and food-borne outbreaks in 2016 ”:
“Two large multicountry outbreaks by Salmonella Enteritidis were reported by 14 member states in the EU in 2016... Available evidence from epidemiological, microbiological, environmental and tracing investigations identified eggs originating from three Polish packing centres as the vehicle of infection in this outbreak.
Control measures were adopted at the farm and distribution level, to limit the spread of the outbreak included banning the placing on the market of table eggs originating from the positive farms and from the concerned Polish packing centres as a precautionary measure. All the specific requirements on flocks of laying hens as laid down in Regulation 2160/2003 were applied as soon as a positive flock was identified by the Polish authorities. New pullets were introduced after the culling of Salmonella-positive flocks and the cleaning and disinfection of the poultry houses, all under the supervision of the Polish authorities. An enhanced surveillance period was established at the EU-level by the international outbreak investigation team coordinated by the ECDC, to monitor the public health impact of control measures, based on WGS of any human isolates characterised by MLVA profiles 2-9-7-3-2 or 2-9-6-3-2”.
Evaluating hygiene and sanitation plans for Campylobacter control?
SecureCheck-Campylobacter is a unique diagnostic tool designed specifically to evaluate and mitigate the risk of Campylobacter contamination in poultry processing. This targeted module of SecureCheck helps manufacturers improve and maintain food safety standards during the manufacturing process.
Using a proprietary package, Diversey food safety specialists carry out a comprehensive appraisal of the production operation, identify risks and provide clear, practical guidance and proven solutions to mitigate the risk of cross-contamination.
References
1 http://www.avec-poultry.eu/annual-reports-overview/ Annual Report 2017; P48.
2 http://eur-lex.europa.eu/legal-content/EN/TXT/HTML/?uri=CELEX:32017R1495&rid=1
3 http://onlinelibrary.wiley.com/doi/10.2903/j.efsa.2017.5077/epdf p215